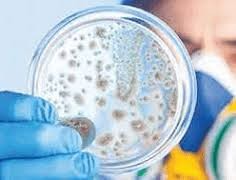

Monitoreos de Agentes Físicos
- Sonometría del ruido.
- Dosimetría de ruido.
- Iluminación.
- Ventilación.
- Estrés térmico, (Calor o Frio).
- Vibraciones de cuerpo entero y de segmento mano-brazo.
- Radiaciones no ionizantes.
- Radiación UV.

Monitoreos de Agentes Químicos
- Monitoreo de Gases.
- Monitoreo de Vapores.
- Monitoreo de Polvos inhalables y respirables.
- Monitoreo de Neblinas.
- Monitoreo de Humos metálicos.
- Monitoreo de Compuestos volátiles (VOC).
- Entre otros.
Monitoreos de Agentes Biológicos
- Hongos, mohos y levaduras.
- Enterobacterias.
- Coliformes totales.
- Coliformes fecales.
- Staphylococcus aureus.
- Aerobios mesofilos.

Monitoreos de Agentes Psicosociales
- Monitoreo de Hostigamiento Psicológico.
- Monitoreo de Estrés laboral.
- Monitoreo de Hostigamiento sexual.
- Monitoreo de Mobbing (acoso laboral).

Monitoreos de Agentes Disergonómicos
- Monitoreo de Manipulación manual de cargas.
- Monitoreo de Sobreesfuerzos.
- Monitoreo de Posturas de trabajo
- .Monitoreo de Movimientos repetitivos.
- Monitoreo de Empuje y Tracción.
- Entre otro.